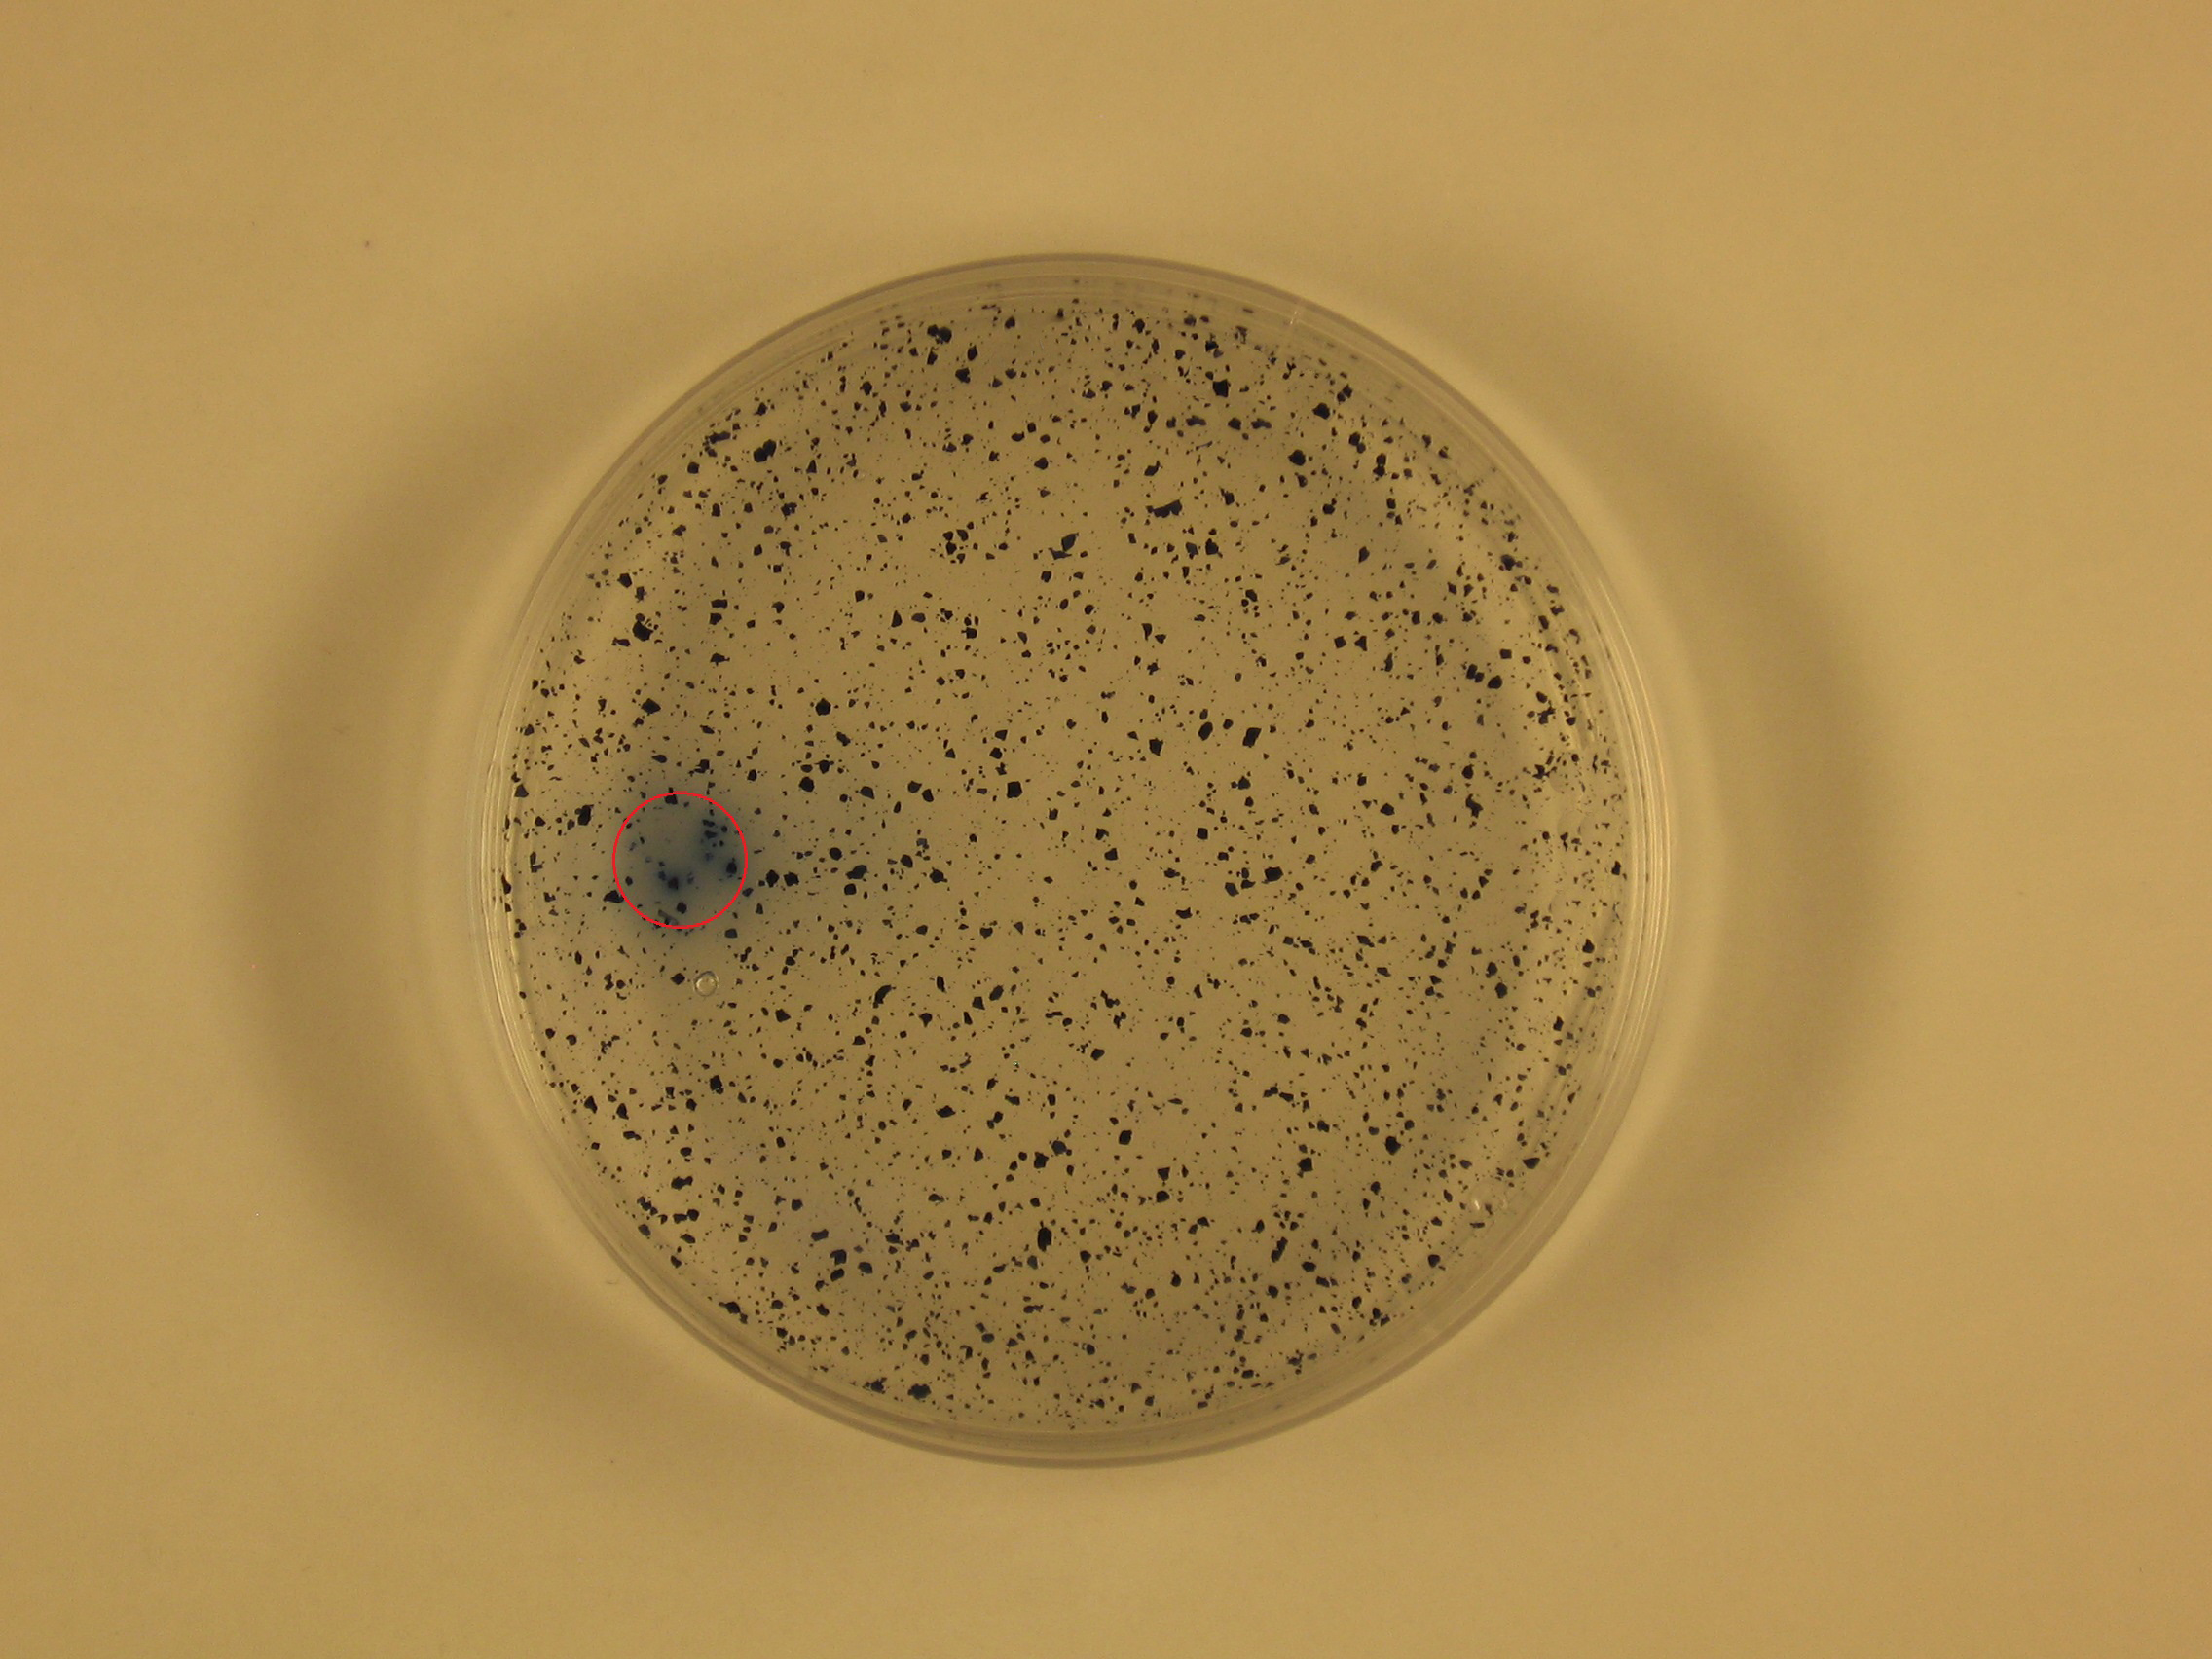

The AZCL-polysaccharides are insoluble chromogenic substrates. They are used at a concentration of about 0.01 – 0.1% w/v in agar plate screening tests. These substrates can be autoclaved. The only AZCL-polymers that are less stable are AZCL-Arabinan and AZCL-Galactan. pH of medium should be in the range of 5-7. If the activity you are screening for is produced by the organism you will get release of dye. Please see the picture attached.
Prepare the required medium for the bacteria of interest and add to it the AZCL-substrates at a concentration of about 0.01 – 0.1% w/v. The media including the substrate should then be autoclaved at 121°C for 15 min. Allow the media to cool to ~ 60°C, swirl the bottle to obtain and uniform mixture of the insoluble substrate and then aseptically pour into a petri dish. Allow the agar to set. The agar plate containing the insoluble substrate is now ready for use.
Product Page (Insoluble Chromogenic Substrates)
Was this article helpful?
That’s Great!
Thank you for your feedback
Sorry! We couldn't be helpful
Thank you for your feedback
Feedback sent
We appreciate your effort and will try to fix the article